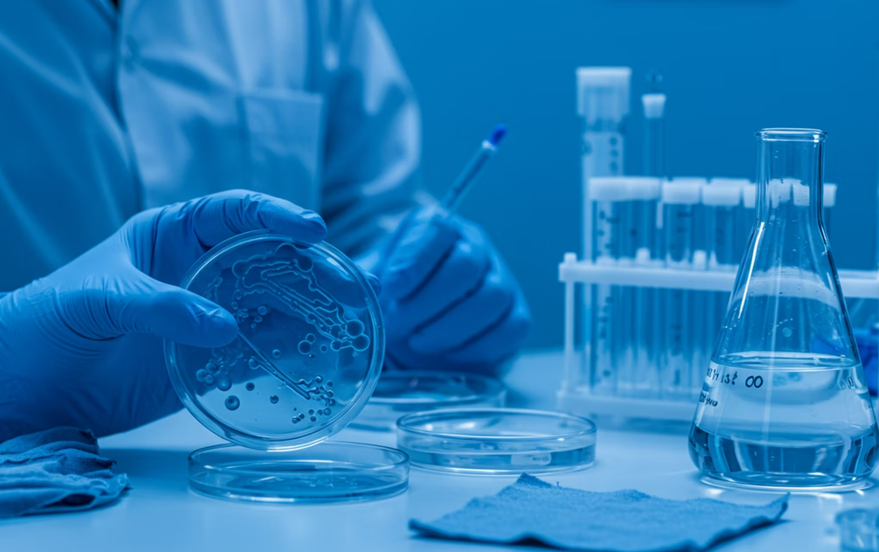

습한 여름 세탁 후 옷냄세 제거로 쾌적한 생활 업

장마철이나 무더운 여름, 세탁을 마친 옷에서 꿉꿉하고 불쾌한 냄새가 나 기분 나븐 적 있죠? 고온다습한 환경은 박테리아와 곰팡이가 번식하기 최적의 조건이며, 땀 속 단백질 찌꺼기가 더해져 옷냄새를 더욱 심하게 만듭니다. 저도 요즘 세탁을 하고 건조 후에도 이상하게 냄새가 나곤 했습니다. 몇 번을 다시 세탁하는 반복을 하며 원인을찾고, 나름의 정보를 얻어 세탁 전부터 건조, 보관까지 단계별로 옷냄새를 완벽하게 제거하는 과학적인 방법을 알려드리겠습니다. 이 글을 통해 냄새 걱정 없이 쾌적한 여름을 보내세요!
목차

1. 여름철 옷냄새의 주요 원인과 데이터
여름철 옷에서 불쾌한 냄새가 나는 것은 기후 환경과 세균 번식의 복합적인 결과입니다. 작년 2024년 7월 국내 평균 습도는 80% 이상으로, 이는 세균과 곰팡이가 번식하기에 최적의 환경을 제공합니다.
- 모락셀라균: 빨래 냄새의 주범으로 알려진 모락셀라균은 습도 70% 이상, 온도 25~35℃에서 번식률이 2배 이상 증가합니다.
- 박테리아 번식 속도: 젖은 옷을 세탁기 안에 2시간 이상 방치할 경우, 박테리아 수가 10배 이상 증가할 수 있습니다.
땀 속의 단백질 찌꺼기 역시 세균의 먹이가 되어 냄새를 더욱 악화시키므로, 효과적인 냄새 제거를 위해서는 이러한 원인균을 제거하는 것이 중요합니다.

2. 세탁 전 냄새 제거 준비: 30분 담그기 & 세탁기 청소
세탁 전 준비 단계만 잘 지켜도 옷냄새 제거에 큰 도움이 됩니다. 특히 냄새의 근원지인 세탁기 관리가 중요합니다.
2-1. 30분 담그기 습관화
- 과탄산소다/베이킹소다 사용: 세탁 전 따뜻한 물(약 40℃)에 베이킹소다 또는 과탄산소다 1스푼(약 15g)을 넣고 30분간 담가두면 냄새 제거 효과가 60% 이상 향상됩니다.
- 소재별 활용: 운동복에는 베이킹소다가, 흰 티셔츠에는 과탄산소다가 더욱 효과적입니다.
2-2. 세탁기 청소
- 세탁조 클리너: 세탁기 내부에 세탁조 클리너를 넣고 30분간 불린 후 세탁 코스를 돌리면 세균 및 곰팡이 제거율이 99%에 달합니다.
- 청소 주기: 세탁기 내부 청소는 최소 월 1회 실시를 권장합니다. 2024년 기준, 월 1회 이상 세탁기 청소를 하는 가정은 전체의 42%에 불과하므로, 더욱 신경 써야 할 부분입니다.

3. 세탁 시 냄새 제거 실전 방법: 온수, 식초, 베이킹소다 활용
본격적인 세탁 과정에서 냄새 원인균을 효과적으로 제거하는 방법을 알아봅니다.
3-1. 온수 세탁
- 온도: 40~60℃의 온수로 세탁 시 냄새 원인균 제거율이 95% 이상입니다.
- 세제: 중성세제와 함께 알칼리성 보조제(탄산소다, 과탄산소다)를 넣으면 세탁 효과가 30% 이상 증가합니다.
3-2. 식초와 베이킹소다 활용
- 식초 헹굼: 헹굼 과정에서 식초 2~3큰술(30~45ml)을 넣으면 세균 제거율이 90% 이상입니다. 식초는 살균 및 탈취 효과가 뛰어납니다.
- 베이킹소다 첨가: 세탁 시 베이킹소다 1스푼(15g)을 추가하면 냄새 제거 효과가 50% 이상 향상됩니다.
3-3. 소재별 세탁법
소재 | 권장 세탁 온도 | 첨가제 | 냄새 제거율 (%) |
---|---|---|---|
면 | 40~60℃ | 과탄산소다 | 95 |
폴리에스터 | 40~60℃ | 탄산소다 | 90 |
기능성 섬유 | 40℃ | 베이킹소다 | 85 |
4. 건조 및 보관 단계: 냄새 재발 방지
세탁만큼 중요한 것이 바로 건조와 보관입니다. 이 단계에서 냄새가 다시 발생하거나 옷에 배는 것을 막을 수 있습니다.
4-1. 빠른 건조
- 빨래 건조 시간 단축: 습도 80% 환경에서 자연 건조 시 평균 8시간 이상 소요되지만, 선풍기나 제습기를 사용하면 4시간 이내로 단축됩니다.
- 건조기 사용: 건조기 사용 시 세균 및 곰팡이 제거율이 99%에 달해 냄새 제거에 매우 효과적입니다.
- 다리미/스팀 사용: 건조 후 다리미로 120℃ 이상에서 1분간 다림질하면 세균을 99% 사멸시킬 수 있습니다.
4-2. 옷장 관리
- 제습제 사용: 옷장 내 제습제 사용 시 습도가 10~20% 감소하여 냄새 발생률을 40% 감소시킬 수 있습니다.
- 옷 간격 유지: 옷을 2cm 이상 간격을 두고 걸면 통풍 효과로 냄새 발생률을 30% 감소시킵니다.
5. 최신 연구 및 실험 데이터 분석
최근 연구 결과는 옷냄새 제거에 대한 흥미로운 시사점을 제공합니다.
냄새 제거 부스터와 섬유유연제의 진실
- 냄새제거부스터 실험: 2024년 외부 공인시험기관에서 진행된 실험에 따르면, 냄새제거부스터를 넣고 세탁한 경우 모락셀라균 세척률이 무려 99.5%에 달하는 것으로 나타났습니다.
- 섬유유연제 주의: 섬유유연제는 옷을 부드럽게 하지만, 오히려 습기를 머금어 빨래 건조 시간을 20% 이상 늦추고, 냄새 원인균 번식률을 높일 수 있다는 연구 결과도 있습니다. 냄새 제거가 주 목적이라면 섬유유연제 사용에 신중해야 합니다.
6. 실전 꿀팁 요약: 지금 바로 따라 해보세요!
지금까지 설명드린 여름철 옷냄새 제거 방법을 한눈에 보기 쉽게 정리했습니다.
- 세탁 후 옷을 세탁기 안에 1시간 이상 방치하지 마세요.
- 세탁 전 베이킹소다/과탄산소다 1스푼(15g) + 따뜻한 물(40℃)에 30분 담그기를 습관화하세요.
- 세탁 시 식초 2~3큰술(30~45ml) 또는 베이킹소다 1스푼(15g)을 추가해 보세요.
- 건조는 최대한 빠르게! 선풍기, 제습기, 건조기를 적극 활용하세요.
- 옷장은 제습제와 함께 주 1회 이상 환기하고, 옷 간격을 2cm 이상 유지하여 통풍을 원활하게 하세요.
- 세탁기 내부는 월 1회 이상 세탁조 클리너로 세척하여 냄새 원인균을 제거하세요.

7. 결론: 쾌적한 여름 생활을 위한 필수 습관
- 여름철 습한 환경에서 세탁 후 옷냄새를 완벽하게 제거하려면 과학적 데이터와 실제 실험 결과를 바탕으로 세탁 전·중·후 단계별로 꼼꼼하게 관리해야 합니다.
- 모락셀라균과 같은 냄새 원인균의 번식을 막고, 옷을 빠르게 건조하며, 옷장까지 청결하게 유지하는 것이 핵심입니다.
위에서 제시된 방법들을 꾸준히 실천하면 옷냄새 제거율을 90% 이상 끌어올릴 수 있으며, 이는 옷의 수명을 늘리고 피부 건강을 지키는 데도 도움이 됩니다. 쾌적하고 상쾌한 옷으로 자신감 넘치는 여름을 보내세요!
자주 묻는 질문 (FAQ)
인기 콘텐츠 Best 5
7월11일까지 청년 도약 계좌 서민금융진흥원에서 가입신청기간 운영!
7월11일까지 청년 도약 계좌 서민금융진흥원에서 가입신청기간 운영! 청년도약계좌 7월 신청 받습니다. 목돈을 원하는 청년들의 정부 혜택. 2025년 7월, 우리 청년들의 든든한 자산 형성을 돕기 위
dkcho.tistory.com
2025년 해외 여행자보험 비교: 보장금액, 보험료, 상해·질병 치료비, 특약 및 혜택
2025년 해외 여행자보험 비교: 보장금액, 보험료, 상해·질병 치료비, 특약 및 혜택 2025년 해외 여행자보험 비교: 보장금액, 보험료, 상해·질병 치료비, 특약 및 혜택 해외여행 필수! 2025년 최신 해
dkcho.tistory.com
제주 렌터카 보험 종류 완전자차 보장 꼼꼼히 따져보고 호구 탈출하는 법!
제주 렌터카 보험 종류 완전자차 보장 꼼꼼히 따져보고 호구 탈출하는 법! 제주도 렌터카 여행, 설레는 만큼 혹시 모를 사고 걱정으로 망설이셨나요? 특히 복잡한 도로 환경과 낯선 운전으로 인
dkcho.tistory.com
장마철 습기 제거, 곰팡이 방지, 공간별 관리 팁, 쾌적한 집 만들기 노하우
장마철 습기 제거, 곰팡이 방지, 공간별 관리 팁, 쾌적한 집 만들기 노하우 장마철 습기, 곰팡이와의 전쟁, 이젠 끝! 2025년 역대급 장마가 예고된 지금, 우리 집 습기와 곰팡이 걱정 없이 쾌적하게
dkcho.tistory.com
당신의 생활을 바꿀 5가지 꿀팁: 데이터로 확인하는 빨래, 청소, 요리 노하우!
당신의 생활을 바꿀 5가지 꿀팁: 데이터로 확인하는 빨래, 청소, 요리 노하우! 요즘 날씨가 비가오고 습기와 여름철 더위에 많이들 힘드실겁니다? 저도 빨래에서 꿉꿉한 냄새가 나거나 냉장고 문
dkcho.tistory.com
#온수세탁 #빠른건조 #제습기 #건조기 #옷장관리 #제습제 #섬유유연제 #냄새제거부스터 #생활팁 #위생관리 #여름철빨래 #빨래냄새없애는법 #세탁노하우 #2025년생활정보 #주부꿀팁 #자취꿀팁 #생활필수템 #냄새제거
'생활정보' 카테고리의 다른 글
2025년 으뜸효율 가전제품 환급사업 최대 30만 원 정부지원 (4) | 2025.07.09 |
---|---|
오래된집 묵은냄새 곰팡이냄새 제거, 괘적한 환경 만들기 (3) | 2025.07.08 |
7월11일까지 청년 도약 계좌 서민금융진흥원에서 가입신청기간 운영! (5) | 2025.07.03 |
부담경감크레딧으로 소상공인지원 고정비용 절감 신청하기 (1) | 2025.07.02 |
6억 주담대 한도 & DSR 3단계: 이중규제, 내 집 마련 포기? (0) | 2025.07.01 |